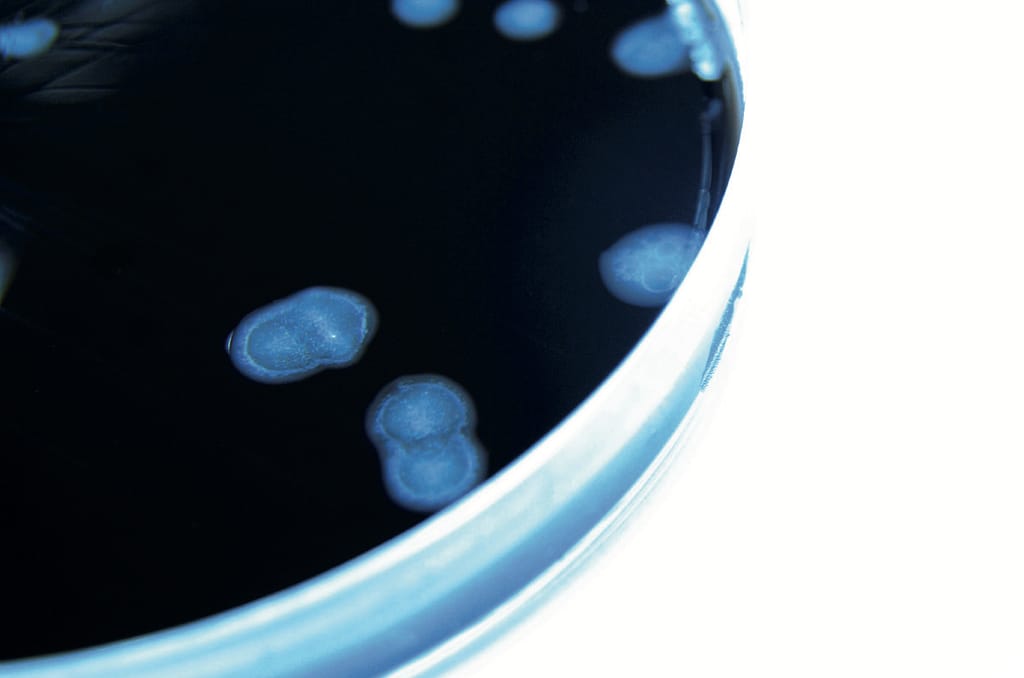
Resistencia transferible a quinolonas en enterobacterias productoras de BLEE en un hospital pediátrico del Uruguay

Revista Bioreview
Edición 25 Septiembre 2013
Lee sobre resistencia transferible a quinolonas en enterobacterias productoras de BLEE en un hospital pediátrico del Uruguay

Lee sobre resistencia transferible a quinolonas en enterobacterias productoras de BLEE en un hospital pediátrico del Uruguay